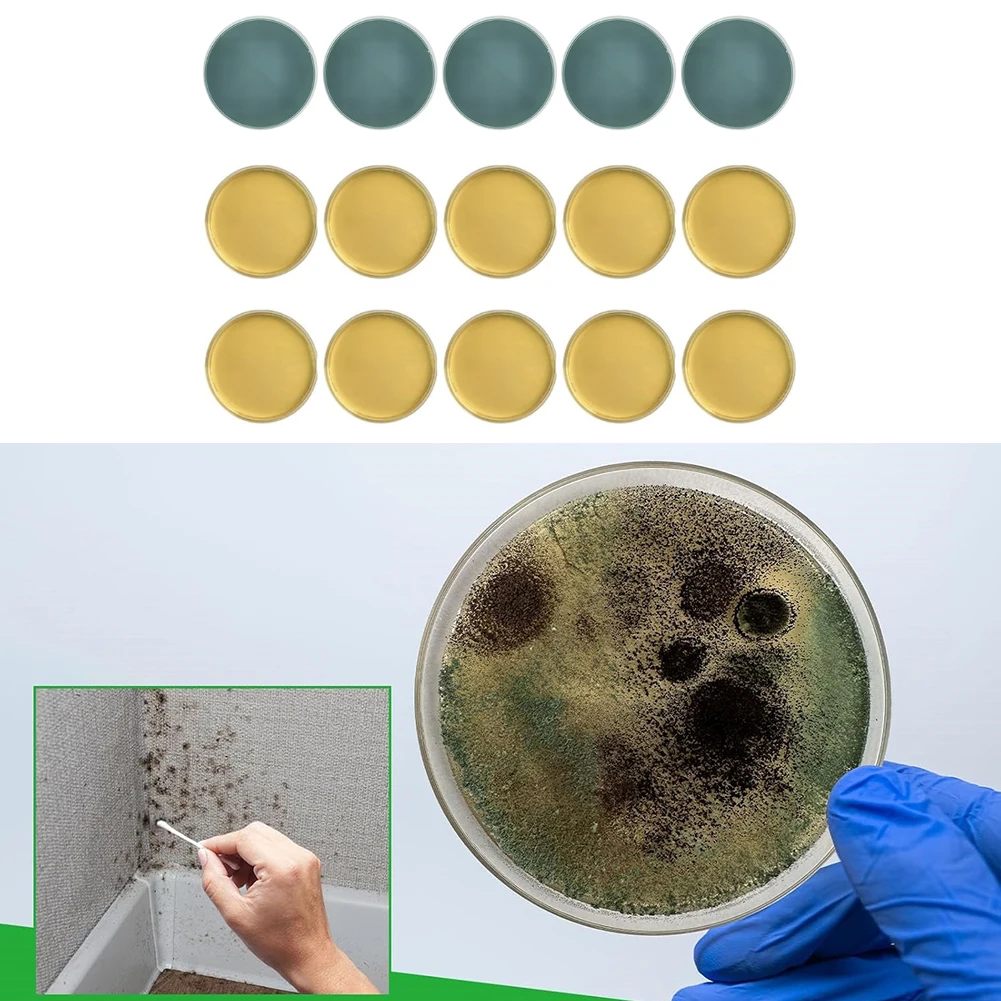
thumb

Home Air Quality Assessment Indoor Air Detector Comprehensive Air Quality Assessment Air Quality Test 5 Agar Plates Included
Price history chart & currency exchange rate
Customers also viewed

$18.26
2024 Продажа изысканный браслет французского бренда 925 Женские Ювелирные изделия подходят для повседневных вечеринок для ношения высококачественные праздничные подарки
aliexpress.ru
$2.50
waterproof bike seat cover bike seat cover waterproof bike seat cover rain bike seat cover for rain bike seat covers
aliexpress.com
$1,248.15
2024 новейшая экономичная Камера-Эндоскоп для осмотра автомобильного двигателя, гибкий Видеоскоп с 5-дюймовым HD ЖК-дисплеем
aliexpress.com
$1,313.04
OUCHI выхлопная система из нержавеющей стали для BMW M340i G20/G28 2017 + 3,0 T B58 с глушителем, токарные выхлопные системы, трубы
aliexpress.com
$12.10
women's blouses shirts womens and blouses elegant long sleeve white ol shirt ladies solid color chemise femme blusa feminina streetwea
dhgate.com
$81.10
loveyou 3color strap bag 3 piece set luxury leather envelope underarm square flap hobo shoulder fashion designer envelope tote messenger cro
dhgate.com
$2.52
ELECOOL Invisible Eyelid Sticker Set Eye Lift Strips Double Eyelid Tape Adhesive Stickers Eye Tape Tools With Glue Tweezers
aliexpress.ru
$72.72
Binbinbird new rotating buckle football shoes children s professional low-top broken nails non-slip comfortable sports grass 30
joom.ru
$42.84
Огнестойкая одежда, огнестойкие, теплостойкие, пожарные, защитные, светоотражающие, брюки XXL XXL
joom.ru
$147.70
2019 factory pizza mascot costume for adults christmas halloween outfit fancy dress suit 4246516, Red;yellow
dhgate.com
$43.43
graphic shirts for men trendy Lapel summer outdoor loose fashion letter Striped Printed button down short sleeve beach party style Hawaii plus size blouse, Customize
dhgate.com
$36.94
2022fw RHUDE Bomb Jacket Men Women Top Version Heavy Fabric Leather Stitching Woolen Coat Rhude Baseball Jacket
aliexpress.com
$0.56
2022 шар, спортивный пузырьковый шар, надувной уличный шар для вечеринки, забавный подарок, надувная игрушка, шар для детей
aliexpress.ru
$29.84
cosmetic bags & cases fashion makeup storage bag animal pattern printing classic women canvas day clutch causal purse
dhgate.com
$38.33
silver needle s925 earrings korea east gate diamond inlaid butterfly simple personality small temperament female, Golden
dhgate.com
$17.61
QIALINO Case for iPhone 7 Genuine Leather Luxury Fashion Leather phone case for iPhone 7 plus flip pure handmade cover 4.7/5.5
aliexpress.com
$41.05
spiked studded leather dog harness chest 26\"-34\" & spiked leather collar for mastiff pitbu bbyotc
dhgate.com
$127.07
noenname_null yellow men suits tuxedos custome homme terno masculino new slim fit men blazer suit (jacket+pant+tie+handkerchief)1, White;black
dhgate.com
$85.61
women's early autumn new light ripe trench windproof coat casual long sleeve solid patchwork turn down collar, Tan;black
dhgate.com
$0.63
mask anti-haze mouth 5 mijkh disposable iia522 mask fa styles kids blocking dust air breathable 3-ply for jtctb camouflage rbmwd
dhgate.com
$91.62
womens bags luxury type leather bucket bag handbag drawstring lady shoulder bags vintage fashion messenger crossbody bags
dhgate.com
$37.40
Beautifical high quality lace fabric embroidered fabric african beaded lace fabric best sales 5 yards french african lace 5N309
aliexpress.com
$75.00
zorssar Women Summer Fashion Rhinestone Slipper Sexy Hollow Out Chunky High Heels Sandals Crystal Party Shoes Woman Flip Flops
aliexpress.com
$94.08
Chrome 10" Ultrathin Showerhead Wall Mounted Shower Faucet Set Rain Bathroom Mixer Tap W/ Tub Spout
aliexpress.com
$7.26
Летний жилет для мальчиков с принтом, одежда для маленьких собак, жилет, футболка, летняя дышащая хлопковая одежда для щенков чихуахуа S
joom.ru
$19.97
1 шт. религиозные убеждения кошерный молитвенный шарф шаль шарф утренние молитвы арабский шарф в полоску
joom.ru
$23.20
Solar With Light Clip Outdoor Use Courtyards Fences Villas Walls Parks Lamp Lawns Warm Light
joom.ru
$11.47
Домашняя собака собака кошка плюшевая мультяшная вышивка устойчивая к укусам декомпрессионная утка поросенок слон милый голос игрушка принадлежности
joom.ru$46.55
Children's Lunch Bags Solid Color Thermal Insulation Large Capacity Outdoor Portable Picnic Food Storage Bag Kids Lunch Box Bag
shopee.co.id
$10.90
Роскошный чехол-кошелек для LG Velvet L-52A Премиальный кожаный чехол для LG Velvet 5G UW Flip Cover Bags Fundas Coque for LG Velvet&Only Case
joom.ru